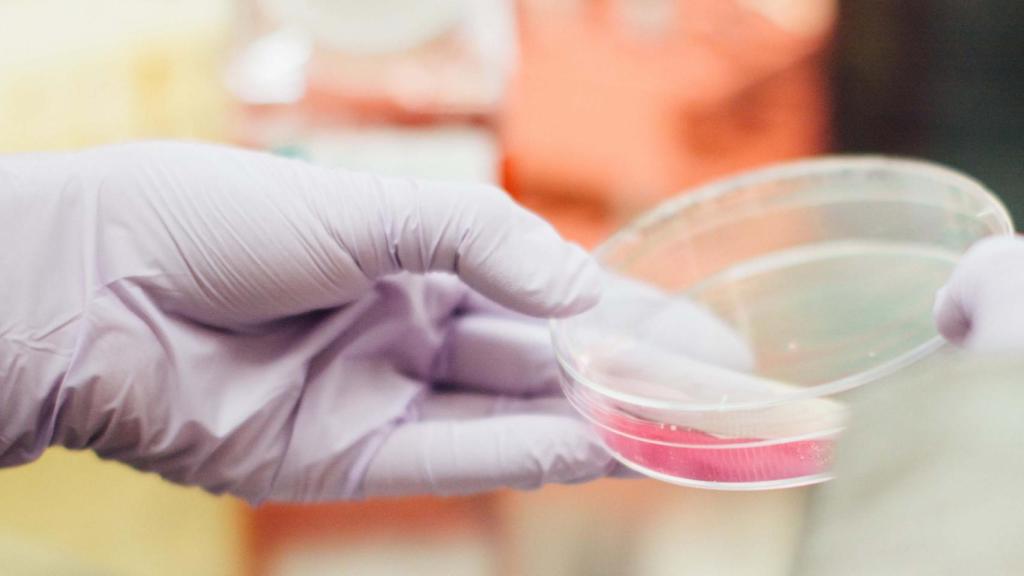
Este nanofármaco español sólo actúa en las células tumorales (no daña las sanas)

Este nanofármaco español sólo actúa en las células tumorales (no daña las sanas)
Este nanofármaco español sólo actúa en las células tumorales (no daña las sanas)
El nuevo medicamento, desarrollado por investigadores del Hospital Sant Pau, la UAB, el CSIC y el CIBER-BBN, funciona como un dron y ha sido ensayado con éxito en animales
Investigadores del Hospital Sant Pau, la UAB, el CSIC y el CIBER-BBN han ensayado con éxito en animales con cáncer de colon metastásico un nanofármaco que actúa sólo sobre las células tumorales y no sobre las células sanas, bloqueando el avance del cáncer.
La investigación, que publica la revista EMBO Molecular Medicine, abre una nueva vía para prevenir la metástasis en el cáncer colorrectal en humanos utilizando una nanomedicina que elimina selectivamente les células madre metastásicas.
Según los investigadores, el nuevo fármaco funciona como un dron que tiene un ligando que identifica un receptor (CXCR4) en las células madre metastásicas, administra el fármaco y destruye estas células bloqueando la metástasis. Al actuar sólo sobre las células tumorales metastásicas, el nuevo nanofármaco evita la toxicidad general asociada a los tratamientos habituales contra el cáncer.
Aunque hasta ahora se ha ensayado con éxito en animales con cáncer colorrectal, los investigadores creen que se podría utilizar en 20 tipos de tumores adicionales que también expresan CXCR4, como en los de próstata, mama, ovario y otros.
Los investigadores han destacado que se trata del "primer fármaco en el mundo selectivamente antimetastásico que aborda la necesidad médica de bloquear la diseminación metastásica", la principal causa de muerte en pacientes oncológicos, "a la vez que elimina la toxicidad y los efectos adversos de los tratamientos convencionales".
Cómo actúa
Los científicos han detallado que el fármaco actúa solo sobre las células iniciadoras de metástasis a través de su interacción específica entre un péptido presente en la nanopartícula proteica que lo transporta y el receptor celular CXCR4 que se encuentra sobreexpresado en las células tumorales. "Esto permite atacar solamente a las células tumorales, bloqueando su diseminación en estadios tempranos, de manera que previene la aparición de metástasis a la vez que evita los efectos adversos derivados de los tratamientos habituales", han detallado.
Los científicos creen que la nanopartícula se puede dirigir para tratar diferentes tipos de neoplasias, convirtiéndola en un vehículo muy versátil que puede transportar diferentes moléculas terapéuticas de elevada potencia para diversos tipos de cáncer.
Actualmente no existen fármacos en el mercado que eliminen selectivamente las células madre metastásicas, por lo que este descubrimiento podría tener un alto impacto clínico después de que se hayan realizado los ensayos necesarios para aplicarse en humanos.
El Hospital de Sant Pau de Barcelona podría ser el primer centro en el mundo en llevar a cabo ahora ensayos clínicos que evalúen este nuevo fármaco en pacientes, previamente a su posible introducción en la terapéutica clínica.
El trabajo ha sido llevado a cabo conjuntamente por investigadores del Institut d'Investigació Biomèdica de Sant Pau (IIB Sant Pau), del Hospital Sant Pau, de la Universidad Autónoma de Barcelona (UAB), del Consejo Superior de Investigaciones Científicas (CSIC) y del Centro de Investigación Biomédica en Red de Bioingeniería, Biomateriales y Nanomedicina (CIBER-BBN), que han sido los creadores del nanofármaco. La investigación ha sido liderada por Ramon Mangues (IIB Sant) y Antonio Villaverde y Esther Vázquez, ambos de la UAB, y todos ellos miembros del CIBER-BBN.



